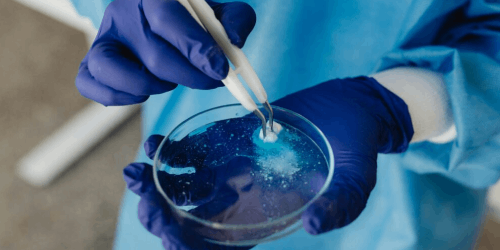

Preservatives Ingredients

SFS EHG
Ethylhexylglycerin

SFS PEHG
Phenoxyethanol & Ethylhexylglycerin

SFS PEG
Phenoxyethanol & Triethylene Glycol

SFS CIT/MIT
Methylchloroisothiazolinone and Methylisothiazolinone
Ethylhexylglycerin

Phenoxyethanol & Ethylhexylglycerin

Phenoxyethanol & Triethylene Glycol

Methylchloroisothiazolinone and Methylisothiazolinone